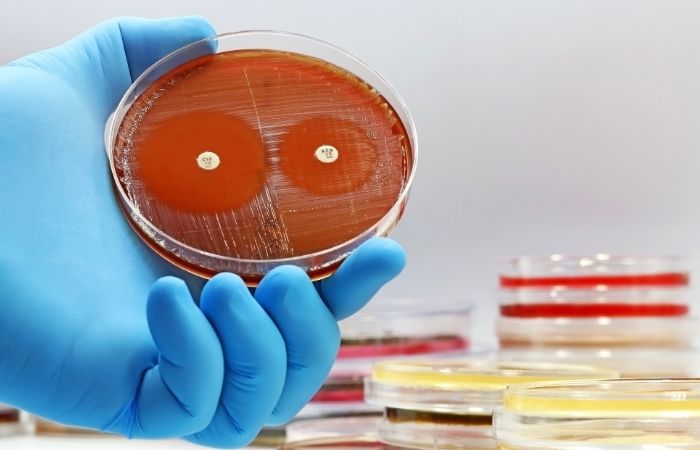

Still Positive After Treatment? Here’s What Might Really Be Going On
Quick Answer: The most effective antibiotics for chlamydia are doxycycline (7-day course) and azithromycin (single dose), but doxycycline is now preferred due to better cure rates and lower reinfection risk.
When It Burns, But It’s Not a UTI
It’s a familiar story: a sting while peeing, maybe a little discharge, maybe nothing at all. The confusion starts early, especially for people with vaginas. They often assume it’s a yeast infection or UTI, both more commonly discussed, both less stigmatized. In fact, over 70% of people assigned female at birth with chlamydia report no symptoms at all, according to CDC data.
But that silence doesn’t mean safety. Left untreated, chlamydia can cause pelvic inflammatory disease (PID), chronic pain, ectopic pregnancy risk, and infertility. In people with penises, it can lead to epididymitis, painful swelling in the testicles, and, rarely, prostate complications. The stakes are real, even if the signs are subtle.
That’s why catching it early, and treating it correctly, is critical. It’s also why so many turn to Google and Reddit threads in a panic, trying to decipher what meds will wipe it out and whether one pill will actually fix the problem.

People are also reading: How to Tell a Hookup You Had an STD After the Fact
Antibiotics for Chlamydia: What Actually Works?
Let’s clear this up: not all antibiotics work for chlamydia. It’s not a generic “take what you have at home” situation. The current gold standard is a class of antibiotics that target intracellular bacteria, because chlamydia trachomatis doesn’t just hang around in fluids. It burrows into cells, quietly replicating.
Historically, the two primary prescriptions were:
Figure 1. Current first-line antibiotics for treating uncomplicated chlamydia. Source: CDC, BMJ, and recent clinical studies.
For years, azithromycin was the go-to because of its simplicity, one pill, done. But new evidence has shifted preferences. A 2021 review in BMJ revealed that doxycycline had consistently higher cure rates, especially for rectal infections. It’s now the preferred treatment recommended by the CDC and WHO, barring any contraindications.
Why Isn’t One Pill Enough Anymore?
Azithromycin’s convenience made it popular, but convenience doesn’t always mean superior outcomes. Especially for people with rectal exposure (regardless of gender), studies showed that azithromycin was more likely to leave behind residual infection, potentially setting the stage for reinfection or transmission.
That matters, not just biologically but emotionally. Getting treatment and still testing positive weeks later is more than frustrating, it’s demoralizing. For many, it reinforces internalized shame or fuels suspicion toward partners. One Reddit user wrote: “I took the pill. Didn’t even hook up with anyone new. And somehow I tested positive again?!”
This isn’t just anecdotal. A 2017 meta-analysis in the Journal of Antimicrobial Chemotherapy confirmed that rectal chlamydia responded better to doxycycline, even in asymptomatic cases. This data helped shift global treatment guidelines to prioritize longer courses with higher reliability.
In short: one pill might be easier, but seven days is more thorough, and less likely to result in a comeback.
“I Thought It Was Gone. Then I Got the Call.”
DeShawn, 28, took azithromycin after his partner tested positive. He got tested at a clinic the next day, was prescribed the standard 1g dose, and didn’t think much of it. Two weeks later, he got a call from the public health nurse: his follow-up swab came back positive again.
“I was pissed. I didn’t do anything in between. They told me I was probably fine, but the infection was still there.”
His frustration is common, and understandable. Reinfection after treatment could mean a partner wasn’t treated, or that the treatment didn’t fully clear the bacteria. In DeShawn’s case, he’d had receptive anal sex during the exposure window. The clinic switched him to doxycycline, and this time, his follow-up was clear.
This isn’t a story about failure, it’s a story about better tools. And it illustrates the shift in how medical systems approach chlamydia: not just treating the infection, but understanding the context.
How Long Does Chlamydia Take to Go Away After Treatment?
Let’s say you start the doxycycline today. Seven days, two pills a day, you don’t miss a dose. When are you actually clear?
Here’s the honest answer: the bacteria is typically cleared within a few days of completing treatment, but the CDC recommends waiting at least 7 days after starting antibiotics before resuming sexual activity. That’s because the body might still be shedding trace amounts of the bacteria, and jumping back into sex too soon could lead to transmission, even if you feel completely fine.
This “wait week” becomes a major stumbling block for many. Not because people are reckless, but because no one tells them why it matters. When sex is tied up in shame, we tend to skip the awkward questions. But we need to normalize them.
In a recent 2020 behavioral study, researchers found that up to 40% of young adults resumed sex before the 7-day window. Many believed that “once I take the pill, I’m safe.” This myth, fueled by vague discharge instructions and rushed visits, leads to unnecessary cycles of reinfection.
Real healing takes more than meds. It takes information people can actually use.
Retesting: When, Why, and What If It’s Still Positive?
The next most-Googled question after “best chlamydia treatment” is: What if I still test positive after antibiotics?
The CDC recommends retesting three months after treatment for anyone diagnosed with chlamydia. Not because the antibiotics fail often, but because reinfection is common, and people deserve to know for sure. This is especially true for those in non-monogamous setups, anyone with untreated partners, or if condoms weren’t used consistently after treatment.
Here’s what that testing timeline typically looks like:
Figure 2. Suggested chlamydia testing and retesting windows. Based on CDC and WHO guidance as of 2024.
It is significant to clarify that standard NAAT (nucleic acid amplification tests) can still detect non viable bacterial residues weeks after successful treatment. This is to say that a test done prematurely could result in a false positive result not because you are actually infected but because your body has not cleared your system of deceased bacterial DNA residues.
That is why symptoms, surrounding factors, and timing are more important than one test result.
But What About Antibiotic Resistance?
This is where things get more complicated. While chlamydia trachomatis hasn't shown the same kind of multidrug resistance as gonorrhea (yet), there are growing concerns about treatment failure in certain populations. Especially with widespread use of azithromycin for unrelated infections like respiratory illnesses, the bacteria has had plenty of exposure to that medication, and plenty of opportunities to adapt.
In 2023, a PubMed analysis flagged regional data suggesting increasing resistance in Southeast Asia and parts of the UK, though U.S. data has not yet confirmed widespread resistance. Still, the trend has prompted more cautious use of azithromycin and reinforced doxycycline as first-line.
It’s also a reminder not to DIY your treatment. Grabbing leftover antibiotics from an unrelated illness or sharing meds with a friend may not just be ineffective, it could help the bacteria adapt in ways that make future treatment harder. And it’s not just you at risk, it’s your whole community.
This is public health and personal health intertwined. That’s why the right diagnosis, the right treatment, and the right timing all matter.
People are also reading: Syphilis or Something Else? How to Tell If That Bump Is Dangerous
Partner Treatment Isn’t Optional, It’s the Cure
One of the most painful truths about chlamydia is how many people get reinfected, by the very partner they trusted. And it’s not because that person cheated. Often, it’s because they didn’t get treated at all. Or they were asymptomatic and didn’t even know they had anything.
The CDC estimates that up to 20% of people treated for chlamydia are reinfected within six months. In one study, even when patients were counseled to notify partners, actual treatment follow-through was inconsistent, especially in casual relationships.
That’s why some clinics now offer expedited partner therapy (EPT), meaning you’re given a second dose of medication to give directly to your partner without requiring them to be seen by a doctor. While not legal in every U.S. state, it’s a proven tool for reducing reinfection and breaking the shame spiral that keeps people silent.
Still, not everyone has access to EPT, or feels safe delivering that conversation. That’s where at-home testing and telehealth tools come in. You can order test kits together. You can check in anonymously. You can get treated without walking into a pharmacy you’d rather avoid. Privacy shouldn’t be a luxury, it should be part of how we care.
Can Chlamydia Go Away Without Antibiotics?
No, and here’s why that myth is dangerous. Despite a few viral TikToks and wellness blog claims about “natural healing,” chlamydia will not disappear on its own. This isn’t a sore throat or a seasonal cold. It’s a bacterial infection that digs into the lining of your reproductive tract, and without proper antibiotics, it can cause lasting damage even if the symptoms vanish.
Studies have shown that while the immune system can sometimes suppress the infection, it rarely clears it completely. In untreated cases, particularly among women and people with vaginas, the infection may silently travel upward, leading to pelvic inflammatory disease. In men, it may damage the vas deferens or lead to chronic testicular pain. Neither scenario is a flex.
There’s also the silent partner effect. You may feel fine, but your body may still be a carrier, transmitting chlamydia to someone else during oral, vaginal, or anal sex. One WHO overview emphasized that most transmissions happen from asymptomatic individuals who assumed they were “low risk.”
Bottom line: antibiotics aren’t optional. They’re the only proven, clinical route to fully eliminate the infection. No amount of cranberry juice, herbal cleanses, or bath soaks will substitute for that.
Pregnancy and Chlamydia: What Changes?
For those who are pregnant, or trying to become pregnant, chlamydia becomes even more critical to detect and treat early. Untreated infection during pregnancy can lead to premature birth, low birth weight, or passing the infection to the newborn during vaginal delivery. The most common outcome? Neonatal conjunctivitis (an eye infection) and infant pneumonia, both of which can have long-term consequences.
That’s why prenatal screening for chlamydia is now standard in many countries. But here’s the rub: many people don’t get prenatal care in the first trimester. Or they avoid it due to stigma, cost, or fear of judgment.
Fortunately, azithromycin is considered safe for use during pregnancy. It’s often chosen over doxycycline, which can interfere with fetal bone and tooth development. While some studies suggest azithromycin may be slightly less effective than doxycycline, the risk to the fetus is the greater concern, and the treatment is adjusted accordingly.
This is one of those rare situations where a single-dose option becomes the better choice, not because it’s simpler, but because it’s safer for two bodies, not one.
When Is It Safe to Have Sex Again?
This question might seem premature, but for most people, it’s a source of major anxiety. If your partner is understanding and patient, great. If not? The pressure to resume sex can lead to rushed decisions, confusing conversations, or worse, reinfecting each other because no one knew the rules.
Here’s the guideline: wait at least 7 full days after starting treatment before having any sex, oral, anal, or vaginal. That includes no sex with a condom. No "just the tip." No “we didn’t go all the way.” None of that counts as safe until the bacteria is gone and your body has stopped shedding infectious cells.
To be even safer, it’s best if your partner gets treated and waits 7 days too. You should ideally both start counting the clock at the same time. If that’s not possible, if you’re not in contact, if they refuse, or if you just don’t know, you should retest after three months no matter what.
In a 2022 review published in Sexually Transmitted Diseases, researchers found that most reinfections could be traced to partners who weren’t treated, or sex that resumed too early. It’s not rocket science. It’s just timing and communication, and most of us were never taught how to handle that with clarity or compassion.
Test, Treat, Prevent: What Actually Works
Let’s pull it all together. You can’t control your past exposures, but you can absolutely control how you move forward. That means testing at the right time, taking the right medication, waiting the right number of days, and making sure your partners do the same.
Here’s what that roadmap looks like:
Figure 3. Five-step roadmap to treating and preventing chlamydia. Based on CDC and WHO guidelines, updated 2025.
And if you’re somewhere between steps right now, if you’re waiting on a call, scared to ask a partner, or still trying to figure out what symptoms mean, it’s okay. You’re not behind. You’re in the process. And that process is allowed to be messy and nonlinear and still worthy of respect.
STD Test Kits offers a discreet way to take that first or final step. Whether you’re retesting or just not sure, peace of mind is a few clicks away.
FAQs
1. Can you actually treat chlamydia without antibiotics?
Nope, and we wish this myth would die already. Chlamydia isn’t like a bad cold you can sweat out or flush with tea. It’s a bacterial infection that lives inside your cells. Without the right antibiotics, it’s not going anywhere, and you’re just giving it more time to mess with your body. We’ve seen Reddit threads and TikToks talking about garlic, apple cider vinegar, or “just drinking more water.” That’s not medicine, that’s wishful thinking.
2. How long before the meds kick in?
You’ll usually start to feel better within a few days of starting antibiotics, especially if you had symptoms like burning or discharge. But don’t let early relief fool you, the bacteria might still be hanging on. That’s why the golden rule is to wait a full 7 days after starting treatment before having sex again. Yes, that includes oral. Yes, even if you use a condom. Don’t outsmart the clock.
3. I feel fine. Do I still need to get treated?
Yes, 100%. Most people with chlamydia feel totally fine. That’s part of what makes it so sneaky, and so easy to spread. You could be symptom-free and still pass it to someone else during sex. Or it could quietly cause long-term damage like fertility issues or chronic pelvic pain. No symptoms ≠ no problem.
4. What if I already took azithromycin once, do I need doxycycline now?
It depends. If you took azithromycin recently and still tested positive (especially after anal exposure), your provider might switch you to doxycycline, which has better cure rates for rectal infections. This isn’t about “stronger” antibiotics, it’s about using the right one for the job. Don't guess. Get tested again and talk to a provider or telehealth service.
5. Is it really that easy to get reinfected?
Unfortunately, yes. One in five people get reinfected within a few months, and it usually happens because a partner wasn’t treated or someone jumped back into bed too soon. The bacteria isn’t playing hard to get. You treat it. Your partner doesn’t. Boom, cycle continues. That’s why follow-up testing around the 3-month mark is so important, even if you feel fine.
6. Can I test too soon after treatment?
Absolutely. If you test again within a few days or even a week after finishing antibiotics, there’s a decent chance you’ll get a false positive. Why? NAAT tests (which are super sensitive) can detect leftover bacterial DNA even after the infection is gone. Give it at least 3–4 weeks post-treatment if you're checking on symptoms, or wait 3 months if you're just confirming you're still clear.
7. Do I really have to tell my hookup I have chlamydia?
It sucks, we know, but yes. It’s the respectful, human thing to do. You don’t have to deliver a speech or call them crying. You can text, use anonymous partner notification tools, or if you're in a state that allows it, give them a treatment dose through Expedited Partner Therapy. It’s about protecting their health and yours, not about blaming or shaming.
8. Can I still get chlamydia if we used a condom?
Sadly, yes. Condoms lower the risk a lot, but they’re not perfect. Chlamydia can be spread through fluids and contact that condoms don’t always cover, especially during oral or if the condom wasn’t on the whole time. They’re a great tool, not a magical force field.
9. Is it safe to treat chlamydia while pregnant?
Yes, and it’s not just safe, it’s important. Chlamydia during pregnancy can cause premature birth or pass to the baby during delivery. Azithromycin is commonly prescribed during pregnancy because it’s effective and safer than doxycycline in that context. Your provider will know what’s best for you and your baby. Don’t delay it.
10. Can I just buy antibiotics online and handle it myself?
Only if it’s through a legit telehealth provider. Self-medicating with leftover antibiotics from your cousin’s sinus infection isn’t it. The dose, duration, and type matter, especially now that antibiotic resistance is creeping in. If you’re embarrassed to go in person, that’s exactly why services like STD Rapid Test Kits exist. Fast, discreet, and no awkward waiting room vibes.
You Deserve Answers, Not Assumptions
Jasmin, 31, got her positive result on a Monday morning before work. She sat in her car, air conditioning blasting, heart pounding. Her mind spiraled: Was it from her last partner? Could she still have sex again? Was she dirty?
"I felt gross. But then I reminded myself: I did the right thing. I got tested. I’m getting treated. That’s more than a lot of people ever do.”
If you're here, you're already taking care of yourself. You’re not broken. You’re not gross. You’re doing what strong, informed people do: taking charge of your health.
This at-home combo test kit checks for the most common STDs quickly, privately, and without judgment. Whether you're retesting or just want clarity, it's a step forward. No waiting rooms. No awkward conversations. Just answers.
How We Sourced This Article: We combined current guidance from leading medical organizations with peer-reviewed research and lived-experience reporting to make this guide practical, compassionate, and accurate. In total, around fifteen references informed the writing; below, we’ve highlighted some of the most relevant and reader-friendly sources.
Sources
2. Chlamydial Infections – Treatment Guidelines | CDC
4. Chlamydia Trachomatis Infection: Diagnosis & Treatment | Mayo Clinic
About the Author
Dr. F. David is a Board-Certified Infectious Disease Specialist with expertise in STI prevention, diagnosis, and management. Their expert knowledge is combined with a no-nonsense approach blended with sex-positivism to make information more accessible to readers both on- and off-grid.
Reviewed by: Olivia Renner, NP-C | Last medically reviewed: November 2025






